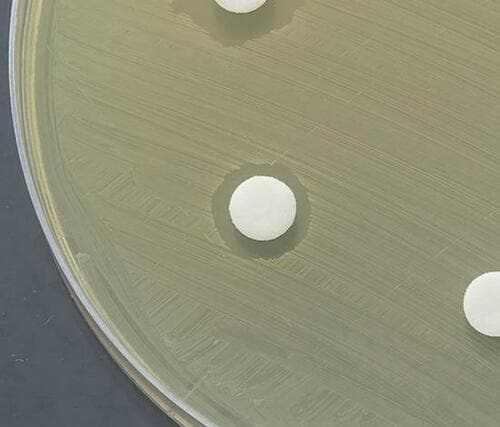
第一三共ヘルスケア「ブレスラボ マウスウォッシュ」 イメージ3

今備えるべき最低限の防災用品を紹介

いつ「首都直下型地震」がいつ起きてもおかしくないと言われていますが、災害への備えはできていますか?
新型コロナウイルスの感染症リスクという新たなハードルができた今、コロナ以前とは災害への備え方が変わってきています。
今回、テストするモノ批評誌『MONOQLO』では、災害や医療のプロに取材を依頼して検証。その結果からわかった今備えるべき最低限の防災用品をご紹介します。
自宅待機で備える!コロナ時代の災害対応策とは?

コロナ時代に災害が発生した場合、倒壊の恐れがある住宅であったり、火災や浸水が想定されるエリアに住んでいない限り自宅で待機することが望ましいです。
その理由としては、
・避難所で感染症にかかるリスクがある
・そもそも避難所のキャパが減っている
などが挙げられます。

国際災害レスキューナースの辻さんによれば、避難所では3密対策として定員を大幅に減らしているとのこと。沖縄・奄美地方などを襲った2020年の台風10号では、「行ったけど入れなかった」とびしょ濡れで立ち尽くす人が続出したそうです。
そのため、コロナ以前とは違い、今では待機できるように家自体を強化したり、自宅からなるべく出なくて済むように備えておくことが必要になります。
そこで今回は、被災時に役立つアイテムをピックアップ。断水に備え、用意しておきたいアイテム4製品をご紹介します。
生活用水が飲み水に!SAWYER PRODUCTS「ソーヤーミニ」

SAWYER PRODUCTS
ソーヤーミニ SP128
実勢価格:3888円
断水時には何よりも飲み水の確保が最優先。たとえ断水が長引いたとしても、備蓄水以外に浄水器があれば、生活用水を飲み水に変換できるので安心です。
実際に被災者からも「断水が長引いて備蓄水では足りなくなり、浄水器で飲み水を確保しました」という声が挙がっていました。

SAWYER PRODUCTS「ソーヤーミニ SP128」は、吸い口部分を取り外せるので、他の容器でも利用できるのが便利です。ろ過率も高く、過去に行った本誌のテストでは、一般細菌や大腸菌をカットし、水道水と同等のろ過効果が実証されています。
水いらずな三陽トレーディング「簡易トイレセット」



三陽トレーディング
SANYO50
簡易トイレセット
実勢価格:4860円
サイズ:W20.5×D21×H10cm
内容量:50回分
保存期間:15年
断水時、トイレは流せなくなる可能性大。そのため、水がいらず、排泄物を固めて捨てられる非常用トイレは必須です。被災者からも「被災地ではトイレ問題が一番つらい。簡易トイレをもらったとき泣きそうになりました」との声が挙がっていました。
三陽トレーディング「SANYO50簡易トイレセット」は圧倒的な消臭力で、臭気判定士も太鼓判を押すほど。そのまま捨てても、翌日もほぼ臭わないので安心して使用できます。
数分でしっかり固まります

はじめに洋式便器に袋を被せ、用を足した後に凝固剤を入れます。

そのまま数分置くだけで、こんなに固まります。

1回ごとにビニールを外してゴミ袋へ捨てれば完了です。

そのまま捨てるので消臭力が重要。SANYOは合格!
マンダム「モワトレ 薬用 デオトラントショット」

マンダム
モワトレ 薬用 デオトラントショット
実勢価格:693円
内容量:70g
※Amazonは2本セットです
被災時には、1週間ほどお風呂に入れなくなることもあります。しかし、水のいらないシャンプーを用意しておけば、ひと安心です。
気になる頭皮のベタつきも、いつでも手軽に解消できます。実際に被災者からも「大震災のとき、ギトギトになった髪がさっぱりするだけで気分が変わった!」との声が。

マンダム「モワトレ 薬用デオトラントショット」をスプレーして揉みほぐすだけで、1日洗っていない頭のベタつきやニオイがスッキリ解消します。気分転換にもなりそうですね。
第一三共ヘルスケア「ブレスラボ マウスウォッシュ」

第一三共ヘルスケア
ブレスラボ
マウスウォッシュ マルチケア
シトラスミント
実勢価格:950円
※パッケージデザインが2021年8月にリニューアルされました。
歯磨き用に使う水がなくても、洗口液ですすぐだけで、ある程度のオーラルケアが可能です。被災者からも「ニオイや健康面の問題もあるが、お口をスッキリさせることでご飯を美味しく食べられた」という声が挙がっていました。

第一三共ヘルスケア「ブレスラボマウスウォッシュ(シトラスミント)」にはカンジダ菌を殺菌し、さまざまな不快臭を消す効果があります。
実際にカンジダ菌を培養するテストでは、ブレスラボを染み込ませた試験片の周囲では、菌が繁殖しにくかったという結果が。歯みがきの代用になるだけではなく、マスクの内側の気になるニオイを抑えてくれるところもうれしいですね。
以上、断水時に向けて備えておきたいアイテム4選のご紹介でした。
防災グッズは一見同じように見えても性能が異なることがあります。今回は、過去ベストバイに輝いた製品に加え、改めて徹底テストしてみてわかった安全なモノだけを厳選してご紹介しているので、ぜひ参考にしてみてくださいね。
▼非常用トイレの比較記事はこちら!




自宅待機の備えがこれまで以上に大事です。